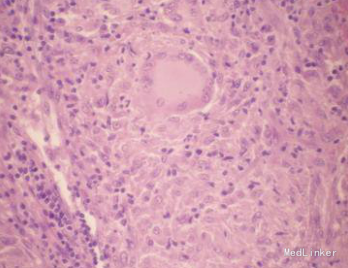

患者,女,38岁。右耳切除植皮术后7年,近1年出现红斑块、出血前来就诊。患者1年前右耳切除位置出现数个黄豆大小的红色丘疹,无痛痒,病变部位随后逐渐增大,破溃后形成溃疡,自行愈合后形成瘢痕。曾于外院诊断为湿疹,予以治疗,未见好转。患者无发热、盗汗、食欲减退、体质量减轻等症状;无咳嗽、胸痛,大小便无明显异常。既往身体健康,无食物、药物过敏史,否认有系统性疾病及慢性病史,否认家族成员有相似疾病史。
查体:一般情况良好,生命体征正常,全身浅表淋巴结未触及肿大,心肺及腹部检查无异常。皮肤科检查:右耳切除处见红褐色浸润性斑块,触之柔软,界限清楚,融合成大瘢痕。实验室检查:血常规、尿常规、肝肾功能均正常,胸部X线检查无异常;结核菌素试验强阳性(硬结直径超过20 mm)。血红细胞沉降率升高。皮损真菌培养阴性,快速血浆反应环状卡片试验(RPR)及梅毒螺旋体血凝试验(TPHA)均为阴性。皮损病理检查显示:表皮棘层肥厚,角化过度乳头瘤样增生,真皮浅层弥漫性淋巴细胞、中性粒细胞浸润。其中可见结节样的上皮样细胞和多核巨细胞,中央可见干酪样坏死。皮损分泌物通过分枝杆菌培养4周阳性,菌型鉴定为结核分枝杆菌。

诊断:皮肤结核寻常狼疮型。临床处理:2HRZE/7HRE。强化期:异烟肼,利福平,乙胺丁醇,吡嗪酰胺连用2个月。巩固期:异烟肼,利福平,乙胺丁醇,连用7个月。患者治疗1个月,斑块及溃疡明显缩小,颜色明显转暗,斑块开始变薄,抗结核治疗9个月后局部斑块全部变平,皮疹全部消失。
皮肤结核是结核分枝杆菌侵犯皮肤或其他脏器,结核病灶累及皮肤引起的皮肤损害,可迁延数年或数十年之久。如果治疗不及时,可能留下损毁性瘢痕。寻常狼疮是一种慢性进行性皮肤结核病,病程可长达数十年。病损常缓慢扩大,可波及大片皮肤,损坏鼻、耳、口唇、眼睑等处,形成瘢痕甚至毁容等。患者的皮损表现为孤立浸润性斑块及结节,结合皮损组织病理检查可确诊为皮肤结核(寻常狼疮)。